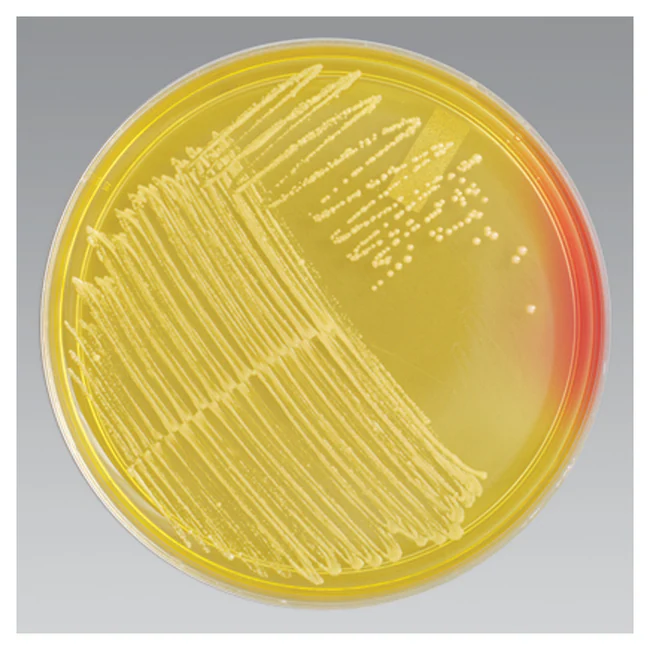
<p>What is the observation and Conclusion of this agar plate?</p>
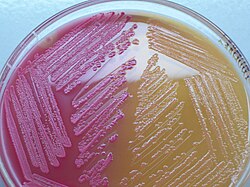
<p>What is the observation and Conclusion of this agar plate? (left vs right)</p>
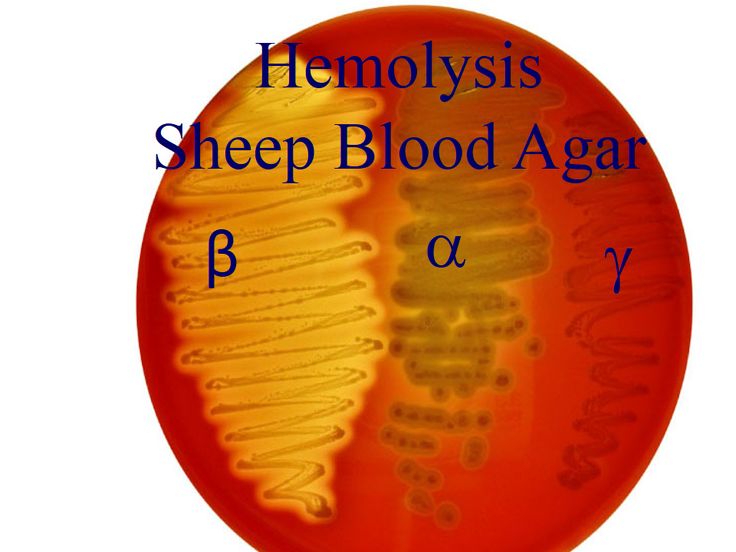
<p>Fill in the blanks:</p><ol><li><p>Alpha hemolysis is a _____ lysis and is ____ around the colony</p></li><li><p>Beta hemolysis is a _______ lysis and is ____ around the colony</p></li><li><p>Gamma (No hemolysis) has no/yes change in medium</p></li></ol><p></p>

Lab #18: Selective, Differential, and Enriched Media
1/18
There's no tags or description
Looks like no tags are added yet.
Name | Mastery | Learn | Test | Matching | Spaced | Call with Kai |
|---|
No analytics yet
Send a link to your students to track their progress
19 Terms
Define:
Selective Media
Contains ingredients that inhibit the growth of some bacteria, while allowing growth of other bacteria
How is selective media useful for microbiologists?
Useful for isolating bacteria from highly mixed contaminated specimens
Define:
Differential Media
Contains ingredients to distinguish one organism from another
How is differential media useful for microbiologists?
Useful to characterize and identify media
Define:
Enriched media
Contains extra nutrients, growth stimulants or growth factors
How is enriched media useful for microbiologists?
Useful to enable fastidious organisms to grow
What type of media/s is Mannitol Salt Agar? Why?
Selective- Sodium chloride (NaCl) makes it so that its concentration is high enough to dehydrate and kill most bacteria
Differential- Mannitol provides the substance for fermentation + phenol red
What bacterial species tolerate the high salt?
Staphylococci
Fill in the blank:
Organisms fermenting mannitol produce _____ and pH indicator turns ____
Acid
Yellow
What color is mannitol not fermented?
pink/red (no color change)
T/F: Staphylococcus aureus ferments mannitol
True
What is the observation and Conclusion of this agar plate?
Growth- Tolerates salt
Yellow- Mannitol fermented
What type of media/s is MacConkey Agar? Why?
Selective- Contains bile salts and crystal violet: these inhibit growth of gram positive bacteria
Differential- Contains lactose and neural red: lactose fermentation bacteria produce acid
The ph indicator turns red at ____
ph less than 6.8
What is the observation and Conclusion of this agar plate? (left vs right)
Growth: Gram negative, pink: fermented lactose
Growth: Gram negative, colorless: no fermentation
McConkey plate is useful in identifying ______
enterics
What type of media/s is Blood Agar? Why
Differential- Useful for identifying which bacteria hemolyze RBC’s
Enriched- Serum + RBC’s provide additional nutrients & growth factors
Fill in the blanks:
Alpha hemolysis is a _____ lysis and is ____ around the colony
Beta hemolysis is a _______ lysis and is ____ around the colony
Gamma (No hemolysis) has no/yes change in medium
incomplete, green
complete, clear
no
Review:
What Media has 7.5% NaCl and has Mannitol and phenol red
What media has Bile slats + Crystal violet and lactose + neutral red
What media has TSA and sheep blood
Mannitol Agar
MacConkey agar
Blood Agar